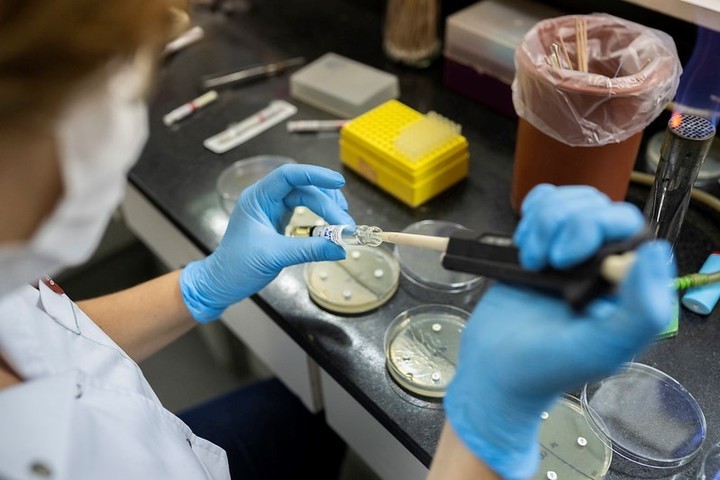

El subclado K de la gripe H3N2 tomó este año a contrapié a la vacuna contra el virus de influenza: la Organización Mundial de la Salud (OMS) ya había definido las cepas que debía contener el fármaco para el invierno boreal. Aunque los expertos aseguran que la inmunización activa funciona igual, sobre todo contra las formas graves de la infección, ahora crece la expectativa por la nueva vacuna y su disponibilidad para aliviar el estrés sanitario de la próxima ola de gripe en el hemisferio sur.
En las últimas horas el Ministerio de Salud de Perú -donde ya detectaron los primeros casos de la supergripe- fue el primero en informar públicamente que el primer lote de una nueva vacuna estará en ese país los primeros días de febrero. Sin embargo, aún no está claro cuándo el fármaco llegará a incluir la cepa mutada. En el Ministerio de Salud argentino se está trabajando en ese sentido, para acelerar los tiempos y arrancar antes.
No obstante, aclararon que la idea de comenzar para esa fecha clave la campaña de vacunación -al menos un mes antes de lo habitual- “depende de la capacidad y stock de los laboratorios, no sólo de las intenciones”. En 2025, la campaña de vacunación contra la gripe se lanzó a fines de marzo, como es habitual, mientras que las inmunizaciones llegaron a sus destinatarios a partir de abril, luego de la distribución de las dosis en las provincias.
A partir de la mayor transmisibilidad del subclado K, es probable que en 2026 la circulación del virus de influenza debajo del Ecuador se adelante, tal como ya ocurrió en el hemisferio norte. Por eso las autoridades buscan anticipar la prevención, sobre todo mediante vacunas destinadas a los grupos de riesgo: menores de 2 años, mayores de 65, embarazadas, profesionales de la salud y personas con comorbilidades.
La novedad se conoce luego de que en el país se registraran los tres primeros casos del subclado K de la gripe H3N2: un niño bonaerense de 5 años y dos adolescentes de Santa Cruz. Luego de esas detecciones, producto de la secuenciación de las muestras que realizó el Instituto Malbrán, Neuquén sumó dos nuevos contagios de personas -un menor y un adulto- que fueron internadas con neumonía y lograron recuperarse.
En los últimos días más países de Sudamérica se agregaron a la lista de los que ya cuentan con presencia de esta variante más contagiosa, que por ser nueva vulnera en parte la inmunidad adquirida.
A la vacuna se añade, la posibilidad de usar el oseltamivir (más conocido como Tamiflu). El Ministerio de Salud advirtió en el último Boletín Epidemiológico Nacional que “el tratamiento antiviral con oseltamivir, un inhibidor de la neuraminidasa, es una herramienta terapéutica complementaria a la vacunación, especialmente útil en pacientes con factores de riesgo”.
Todavía no se sabe cuándo estará disponible la nueva composición de la vacuna contra la “nueva” gripe.